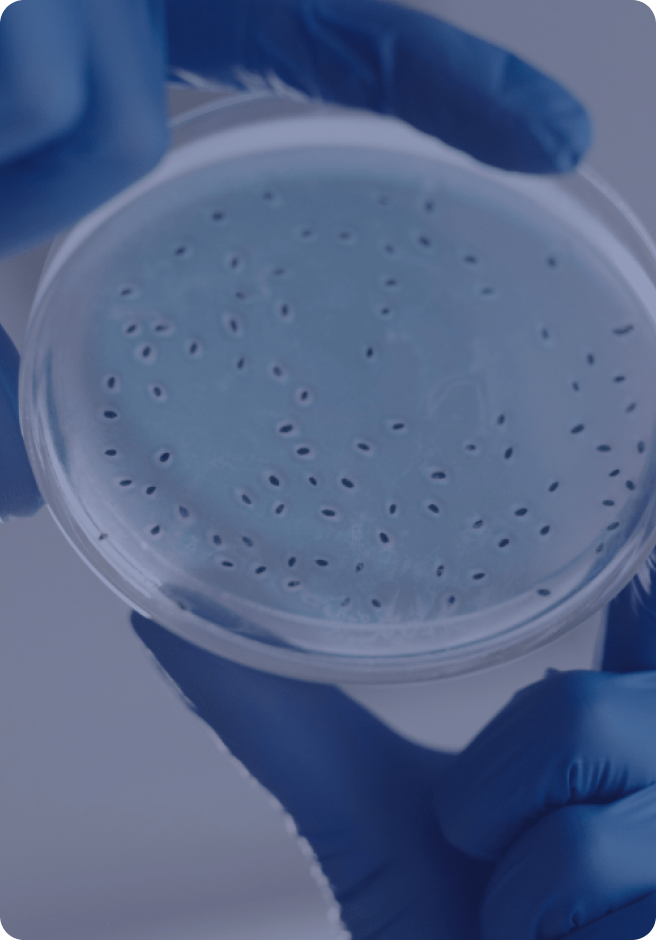
마이크로바이옴 연구

HEALTHY LIFEFORWARD

과학에 기반한 맞춤형 솔루션으로 선사하는
일상의 긍정적 변화는 단순한 구호가 아닌,
여러분과 함께하는 우리의 도전입니다.
최첨단 기술과 의료 전문가들의 협력을 바탕으로
누구나 쉽게 접근할 수 있는 디지털 플랫폼을 통해
종합적인 건강관리 서비스를 제공합니다.
몸과 마음의 온전한 균형을 위해,
언제 어디서나 가까이에 있겠습니다.
헥토헬스케어와 함께라면,
더 건강하고 행복한 내일을
만나실 수 있습니다.

대표 김석진


삶에 대한 자부심
오늘날을 살아가는 모든 사람들이 각자의 삶에 자부심을 느낄 수 있도록 자율성과 주체성을 지속 부여합니다.



건강에 새로운 기준을 만들어갑니다.
건강식품부터 헬스케어까지

건강기능식품
과학적 혁신과 전문성을 바탕으로 일상에 건강한 변화를 가져옵니다. 프리미엄 프로바이오틱스 드시모네와 맞춤형 종합건강기능식품 김석진LAB 등 다양한 제품들로 더욱 건강하고 활기찬 매일을 경험해 보세요.

디지털헬스케어
건강기능식품 추천부터 종합적인 건강관리 전략까지, 헥토헬스케어의 디지털 플랫폼은 여러분의 24시간 건강 파트너로 기능합니다. 언제 어디서나 자신의 상태를 확인할 수 있고, 복잡한 관리도 쉽고 즐거운 일상이 됩니다.
마이크로바이옴 연구
방대한 균주은행과 대변은행, 분석 기술, 한국인 특화 데이터를 바탕으로 신속한 효능 평가와 맞춤형 마이크로바이옴 분석 서비스를 제공하며, 엄격한 임상시험과 규제 대응을 통해 혁신적이고 안전한 기능성 제품을 개발합니다.
WE AREVITALMOTIVATOR
매일 아침, 새로운 건강의 문을 열어드리겠습니다.
바쁜 일상 속 활력을 불어넣겠습니다.
우리는 획일화된 해답을 제시하지 않습니다.
대신, 당신의 생활 방식에 꼭 맞는 맞춤형 솔루션을 함께 찾아갑니다.
당신의 일상에 활력을, 건강에 동기를, 삶에 균형을.
헥토헬스케어는 그 모든 순간에 함께하며,
모두의 건강 권리를 지키는 파트너이자 건강한 삶의 원동력이 되겠습니다.
Brands
De Simone
국내 1위 보장균 수, 고함량 프로바이오틱스
장면역, 국내유일

김석진LAB
과학적 설계로 완성된 종합 건강기능식품
장면역, 국내유일

O2Booster
루틴이 만드는 진짜 회복
산소부스터, 1%의차이

온리추얼
가벼운 일상을 만드는 습관
밸런스, 일상의 균형

About
Info
주식회사 헥토헬스케어대표 : 이경민, 김석진
주소 : 서울특별시 강남구 테헤란로 223, 5층 (역삼동, 큰길타워빌딩)건강기능식품 판매업 : 제2013-0050453호
통신판매업 : 제2015-서울강남-03602호
사업자등록번호 : 209-81-58898
개인정보보호책임자 : 이옥선
[KOR] 이메일 : admin_hc@hecto.co.kr
신규 거래 문의 : 1811-0171
[ENG, CHN] 이메일 : h_ob@hecto.co.kr
Copyright HECTO Healthcare co., Ltd. All right reserved.
